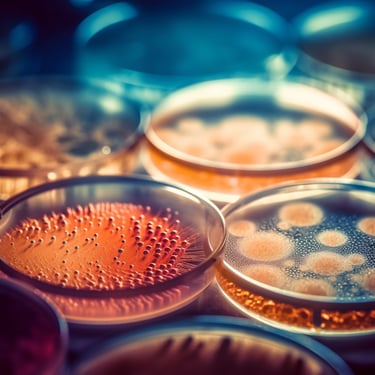
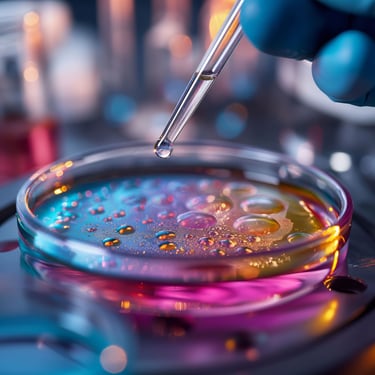
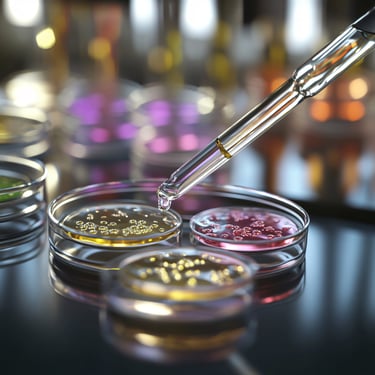

Your Trusted Partner in Pre Clinical CRO
Edara Life Sciences Pvt. Ltd. (ELS) is a stand-alone Contract Research Organization (CRO) located in Hyderabad, India, committed to aiding the industry with regulatory data generation and research initiatives.
About Us
Certified under NABL ISO/IEC 17025:2017, ELS operates a cutting-edge testing facility specializing in the evaluation of Medical Devices, Ayurvedic Drugs and Herbal Formulations.
Our advanced infrastructure is designed to deliver accurate, reliable, and regulatory-compliant data, empowering our clients with actionable insights. Backed by a team of experienced scientists with deep expertise in medical device testing and toxicological assessments, ELS is positioned to serve both domestic and global markets with integrity and scientific excellence.